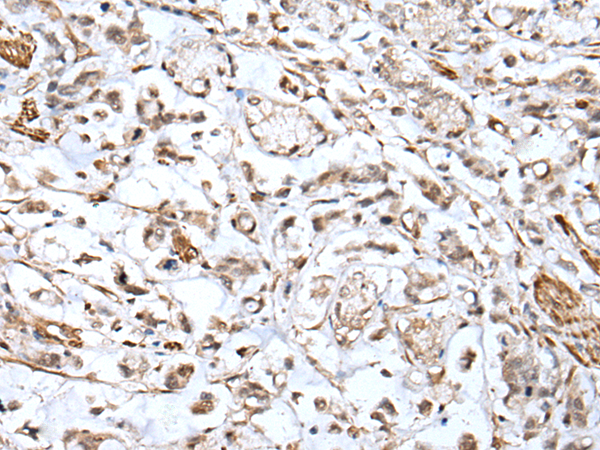

別 名: heat shock protein family B (small) member 2; MKBP; HSP27; Hs.78846; LOH11CR1K
抗 原: HSPB2
宿 主: Rabbit
反應(yīng)種屬: Human, Mouse, Rat
克隆類型: rabbit polyclonal
Background:
The protein encoded by this gene belongs to the superfamily of small heat-shock proteins containing a conservative alpha-crystallin domain at the C-terminal part of the molecule. The protein is expressed preferentially in the heart and skeletal muscle. This protein regulates Myotonic Dystrophy Protein Kinase, which plays an important role in maintenance of muscle structure and function.
Applications:
ELISA, IHC
Name of antibody:
HSPB2
Immunogen:
Fusion protein of human HSPB2
Full name:
heat shock protein family B (small) member 2
Synonyms:
MKBP; HSP27; Hs.78846; LOH11CR1K
SwissProt:
Q16082
ELISA Recommended dilution:
5000-10000
IHC positive control:
Human esophagus cancer
IHC Recommend dilution:
100-300
技術(shù)規(guī)格

購(gòu)物車
幫助
021-54845833/15800441009
